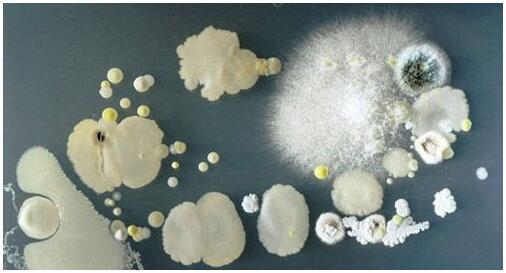
手機(jī)表面細(xì)菌

※ 納米白金涂料納米抗菌劑優(yōu)異的有機(jī)物氧化分解性能可以將霉菌、大腸菌、黃色葡萄菌等滅菌消除!同時(shí)還有抑菌的效果,對(duì)于醫(yī)院內(nèi)的感染防治也起輔助作用。
※ 納米白金涂料納米抗菌劑可用于手機(jī)等數(shù)碼產(chǎn)品表面,有著顯著的抗菌抑菌作用。
手機(jī)表面除菌抗菌的必要性
現(xiàn)在,手機(jī)已經(jīng)是人們的必需品了,24小時(shí)機(jī)不離身,超越了伴侶一般的存在,然而這些手機(jī)一刻也不離身的同學(xué)們可要注意啦!你知道你的手機(jī)有多臟嗎?說(shuō)出來(lái)恐怕嚇你一跳,美國(guó)斯坦福大學(xué)的一項(xiàng)研究報(bào)告顯示,在30款手機(jī)樣品中,觸屏手機(jī)的細(xì)菌和病毒量是男洗手間的18倍,沒錯(cuò),是18倍,成了病菌傳播的媒介。

為了驗(yàn)證手機(jī)有多臟,湖南師大的博士也做了一個(gè)實(shí)驗(yàn),他抽查了6個(gè)樣板手機(jī)、4個(gè)馬桶。最終得出,6個(gè)樣板手機(jī)中每部手機(jī)平均有2500個(gè)細(xì)菌數(shù)量/平方厘米;而馬桶細(xì)菌數(shù)量最多的僅有440個(gè)/平方厘米。手機(jī)不僅比馬桶沖水手柄臟,甚至比馬桶坐墊還要臟。

手機(jī)成了病菌傳播的媒介。打電話時(shí),臉上的油脂、皮屑、汗液會(huì)粘到手機(jī)屏幕上;用臟的雙手在觸屏上來(lái)回滑動(dòng),這些都為病菌的大量滋生提供了有利條件。比如用接觸過(guò)手機(jī)的手揉眼睛、擦鼻子,或是不洗手直接去拿食物吃,就可能將手機(jī)上的病菌帶入體內(nèi),引起各種疾病,比如腹瀉、感冒、眼部感染等。

據(jù)相關(guān)試驗(yàn)數(shù)據(jù)所示,手機(jī)表面的病菌多達(dá)數(shù)十種,建議每隔三個(gè)月到半年更換一次貼膜。如果在如廁時(shí)用過(guò)手機(jī)或?qū)⑹謾C(jī)借給過(guò)別人使用,建議立刻消毒。有沒有更徹底的做法呢?當(dāng)然有,那就是在手機(jī)表面使用青山新材納米白金抗菌涂料,能較持久的使手機(jī)表面抑制病菌的生長(zhǎng)和繁殖。
納米白金涂料可以24小時(shí)365天,全天候在基材表面抗菌殺菌

黃色葡萄球菌試驗(yàn)結(jié)果

大腸桿菌抗菌試驗(yàn)結(jié)果

抗菌時(shí)效性及檢測(cè)方法
抗菌功能可保持2.5年,屬半永久型,不遭受惡意破壞的前提下可以保持更久
抗菌檢測(cè):用不同的棉棒沾水后在玻璃板不同的地方刮一下,用簡(jiǎn)易測(cè)量菌數(shù)的儀器測(cè)定菌數(shù)。(顯示0個(gè))


菌數(shù)、菌的種類請(qǐng)用戶用用戶的方式自行檢測(cè),簡(jiǎn)易測(cè)量的數(shù)值只能作為參考。
該納米白金抗菌涂料涂層超薄,固化快,抗菌性能半永久,完全符合環(huán)境法規(guī),是一種安全的環(huán)境友好型涂料。安全等級(jí)達(dá)到食品級(jí),通常也用于食品、化妝品、藥品,是一種安全的催化劑。
詳情產(chǎn)品情況請(qǐng)致電400-7777-029了解。
